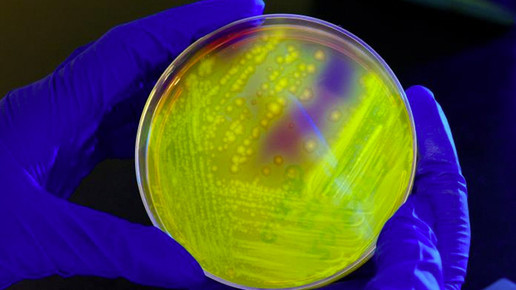

Apotheken-App gegen Resistenzen
Antibiotika-Resistenzen eindämmen und die Beratungskompetenz des Apothekers stärken: Das hat sich „Antibiotika.Coach“ auf die Fahne geschrieben. Der digitale Helfer wird pünktlich zum Welt-Antibiotikatag in der nächsten Woche den Apotheken zur Verfügung stehen.
Der „Antibiotika.Coach“ soll den Patienten helfen, Antibiotika richtig einzunehmen. Jeder Apotheker erhält den digitalen Helfer kostenlos. In Deutschland wird das Tool gemeinsam mit dem offiziellen Partner 1 A Pharma zur Verfügung gestellt. Benötigt werden eine ärztliche Verschreibung und ein Smartphone. Der Apotheker gibt in seinem Cockpit die Kontaktdaten des Kunden und das Rezept ein – die Software erstellt anhand der Daten ein personalisiertes Programm. Der Patient erhält dann per E-Mail oder SMS einen Link zur App, die er dann herunterladen kann.
Der Patient wird dann virtuell vom „Antibiotika.Coach“ über die gesamte Therapiedauer begleitet. In dieser Zeit stellt die App sicher, dass das Arzneimittel zum richtigen Zeitpunkt eingenommen und nicht vergessen wird. Der Patient kann außerdem Informationen wie Neben- und Wechselwirkungen sowie Eigenschaften über das Arzneimittel abrufen – oder Kontakt mit dem Apotheker aufnehmen. Der Patient wird nicht somit nur virtuell, sondern auch persönlich vom Fachpersonal begleitet. So soll ein vorzeitiger Therapieabbruch oder eine unregelmäßige Einnahme verhindert werden.
Die App kann nur mit der Anmeldung durch den Apotheker auf der Basis einer ärztlichen Verschreibung genutzt werden. Der Antibiotika.Coach ist eine nicht-diagnostizierende, präventiv unterstützende mobile Applikation für iOS und Android und ist als Medical Device der Klasse I nach Medizinprodukte-Richtlinie zertifiziert. Entwickelt wurde das Tool von Ärzten und Pharmazeuten.
In der Schweiz wird der Coach bereits von der Apothekenkooperation TopPharm eingesetzt. Hier ist Pfizer als Partner an Bord. Weitere Apps zum Beispiel zur Begleitung von Patienten mit Diabetes oder Bluthochdruck sind geplant. Hinter dem Projekt steht die Firma Doc.Coach aus Basel, deren Investor wiederum die „Brückenköpfe“ aus Berlin sind.
Die Firma versteht sich als „Think Tank und Entscheidungsagentur“ für Ideen im Gesundheitswesen. Kunden sollen Krankenkassen, Konzerne, Interessenverbände und die Politik werden. Allerdings investiert das Unternehmen auch in eigene Beteiligungen. An der Spitze des Beratungs- und Beteiligungsunternehmens stehen Harm van Maanen, der ehemalige AOK-Chef Jürgen Graalmann, der frühere Berliner Gesundheitssenator Mario Czaja, TV-Arzt Eckart von Hirschhausen sowie Max Broglie, Rechtsanwalt und Geschäftsführer der Deutschen Gesellschaft für Innere Medizin (DGIM), Unternehmer Oliver Hagedorn und Ex-Fußballprofi Philipp Lahm.
In Deutschland sterben nach Angaben des Bundesgesundheitsministeriums jedes Jahr zwischen 7500 und 15.000 Menschen, weil sie eine Infektion erleiden, bei denen Antibiotika versagen. Das ist ein Vielfaches der Zahl von Todesopfern im Straßenverkehr. „Unsere Aufgabe ist es, dass die Antibiotika-Therapie nicht vorzeitig abgebrochen wird, um einem Rückfall oder der Bildung von Antibiotika-Resistenzen entgegenzuwirken“, sagte Bundesgesundheitsminister Hermann Gröhe (CDU) im Februar der Apotheken Umschau. „Wir alle müssen mehr tun: in der Verschreibungspraxis, in der Anwendungsberatung. Aber auch die Patienten.“

APOTHEKE ADHOC Debatte